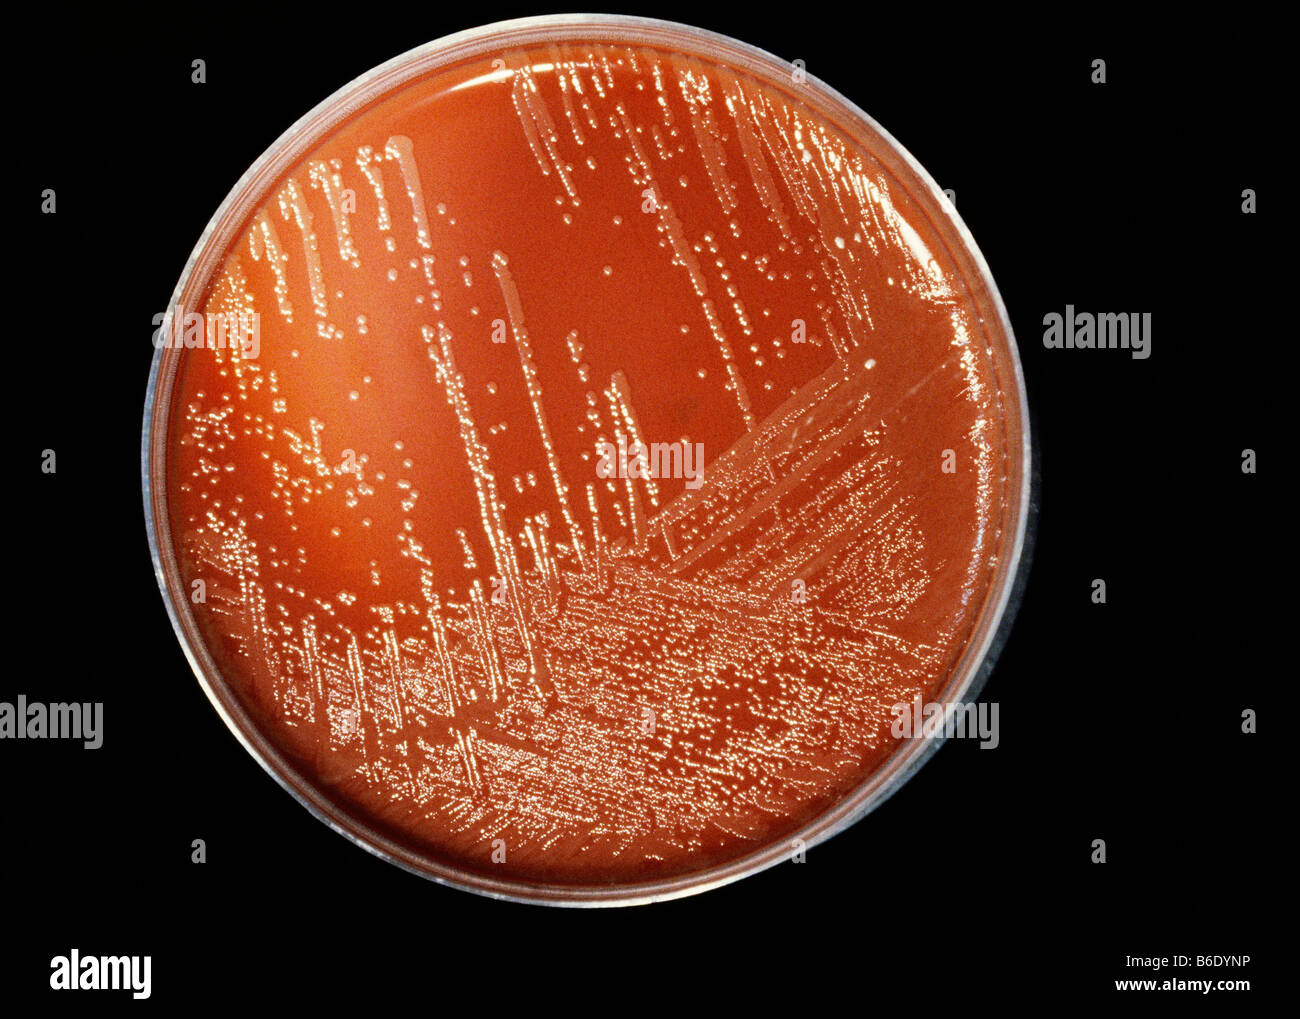
Meningitis-Bakterien. Neisseria Meningitidis Kolonien (weiß) auf einem Agar Wachstumsmedium (braun) in einer Petrischale kultiviert wird. Stockfoto

Schnellfilter:
Neisseria meningitidis Stockfotos & Bilder

RFHP76FA–Neisseria Meningitidis oder Meningococcus ist ein Bakterium, die Meningitis und andere Formen der Meningokokken-Erkrankungen verursachen können.

RF3BKFM79–Neisseria meningitidis-Antikörperbluttest. Identifiziert Antikörper gegen Neisseria meningitidis-Exposition gegenüber den Bakterien, was möglicherweise auf eine frühere Infektion, Impfung oder eine aktuelle Infektion hindeutet.

RF2WC14D8–Kairo, Ägypten, 11. Januar 2024: Nimenrix-Impfstoff gegen invasive Meningokokken-Krankheit, verursacht durch das Bakterium Neisseria meningitidis und gereinigtes Polum

RFPCW3PM–Neisseria meningitidis Gehirn Infektion, computer Abbildung. N.-meningitidis-sind Gramnegative diplokokken (kugelförmige Bakterien paarweise angeordnet), über die Atemwege Route übertragen. In den meisten Menschen, die Sie führen entweder asymptomatische Infektionen oder schwere nasopharingitis, können aber auch schwere Meningitis verursachen und generalisierte Infektion (meningococcaemia), besonders bei Kindern. Ihre Oberfläche ist mit pilli, die Teil der in Anhang von Bakterien, Zellen und Oberflächen werden abgedeckt.

RFPTX86P–Neisseria meningitidis oder Meningococcus ist ein Bakterium, das Meningitis und andere Formen der Meningokokken-erkrankung führen kann. 3D-Darstellung

RF2M1HJCM–3D-Bild einer Minocyclin-Skelettformel - molekularchemische Struktur eines auf weißem Hintergrund isolierten Tetracyclin-Antibiotikums

RMBPFPH9–Fuß eines Patienten infiziert mit dem Bakterium Neisseria Meningitidis, Hauttumoren und Blutungen unter der Haut

RF2WXRF49–Die 3D-Rendering von Neisseria meningitidis, auch als Meningokokken bekannt, ist ein Bakterium, das Meningokokken-Erkrankungen verursacht

RF2HXJ4FJ–Struktur des äußeren Membranproteins PorB aus Neisseria meningitidis mit einer vermeintlichen Membran dargestellt. 3D Cartoon- und Gaußsche Oberflächenmodelle, PDB 3vzt

RF2BRCG79–Wissenschaft Foto von Bakterien Neisseria meningitidis, oft als Meningococcus bezeichnet, ist ein Gram-negatives Bakterium, das Meningitis verursachen kann

RF2SXD193–Neisseria meningitidis (Meningococcus)-Bakterien im Gehirn (Meningitis-Infektion) - 3D-Darstellung einer isometrischen Ansicht

RM2X92B18–Meningokokken oder Meningokokken-Krankheit oder Neisseria meningitidis, ist ein an Meningitis beteiligtes Bakterium. Diese Bakterien sind die Ursache einer leichten Pharyngitis und nur eine von etwa 400 Personen wird Opfer einer schweren Meningokokkeninfektion, meist in Form einer akuten eitrigen Meningitis. Bild aus optischer Mikroskopie. Meningokokken 016813 022

RF2PM75T4–Neisseria meningitidis (Meningokokken)-Bakterien im Gehirn (Meningitis-Infektion) – 3D-Darstellung der Nahaufnahme

RF2M21YEP–3D-Bild einer Chloramphenicol-Natrium-Succinat-Skelettformel - molekularchemische Struktur eines auf weißem Hintergrund isolierten Breitbandantibiotikums

RF2PM75T8–Neisseria meningitidis (Meningococcus)-Bakterien im Gehirn (Meningitis-Infektion) - 3D-Darstellung einer isometrischen Ansicht

RF2K97862–3D Bild der Skelettformel von Rifampicin - molekularchemische Struktur des Ansamycin-Antibiotikums, isoliert auf weißem Hintergrund

RF2WCTR0F–Neisseria gonorrhoeae-Erreger. Sexuell übertragbare Krankheit und Gonokokkeninfektion. Infektionen des Genitaltraktes. Vektorposter

RF2WC13WX–Kairo, Ägypten, 11. Januar 2024: Nimenrix-Impfstoff gegen invasive Meningokokken-Krankheit, verursacht durch das Bakterium Neisseria meningitidis und gereinigtes Polum

RFPCW3PN–Neisseria meningitidis Gehirn Infektion, computer Abbildung. N.-meningitidis-sind Gramnegative diplokokken (kugelförmige Bakterien paarweise angeordnet), über die Atemwege Route übertragen. In den meisten Menschen, die Sie führen entweder asymptomatische Infektionen oder schwere nasopharingitis, können aber auch schwere Meningitis verursachen und generalisierte Infektion (meningococcaemia), besonders bei Kindern. Ihre Oberfläche ist mit pilli, die Teil der in Anhang von Bakterien, Zellen und Oberflächen werden abgedeckt.

RF2JAJN01–Biomedizinische Darstellung der Neisseria meningitidis, einer bakteriellen Meningitis, an der Oberfläche.

RF2DH784P–Neisseria gonorrhoeae (gonococcus) ist eine gram-negative Diplokokken Bakterien verursacht die Sexuell übertragbare Urogenitalinfektion - Gonorrhoe

RMAMCR8A–Ein Foto einer petechiale Ausschlag auf dem rechten Augenlid einer Person infiziert mit dem Bakterium Neisseria menigitidis

RF2WXRF48–Die 3D-Rendering von Neisseria meningitidis, auch als Meningokokken bekannt, ist ein Bakterium, das Meningokokken-Erkrankungen verursacht

RF2JRT8K8–Meningitis ist eine Infektion der schützenden Membranen, die das Gehirn und das Rückenmark umgeben. Gehirn des Menschen mit Hirnhäuten

RM2X92AF2–Meningokokken oder Meningokokken-Krankheit oder Neisseria meningitidis, ist ein an Meningitis beteiligtes Bakterium. Diese Bakterien sind die Ursache einer leichten Pharyngitis und nur eine von etwa 400 Personen wird Opfer einer schweren Meningokokkeninfektion, meist in Form einer akuten eitrigen Meningitis. Bild aus optischer Mikroskopie. Meningokokken 016813 023

RF2AJ617J–Bakterielle Meningitis schreibt am Haftnotiz auf Büro Schreibtisch isoliert. Healthcare oder medizinisches Konzept

RF2FYN0MG–Gonorrhoe News.Nachrichten auf dem Handy.Handy in den Händen. Selektiver Fokus und chromatische Aberration Effekte.

RF2BRCG74–Wissenschaft Foto von Bakterien Neisseria gonorrhoeae, auch bekannt als Gonokokken, oder Gonokokken ist eine Art von Gram-negativen Diplokokken Bakterien

RF2RAKK0K–Meningitis-Bakterien, Neisseria meningitidis. Meningokokken-Meningitis ist eine bakterielle Form der Meningitis, eine schwere Infektion der dünnen Auskleidung

RF2HE1C64–Struktur des Transferrinbindungsproteins A (grün) aus Neisseria meningitidis, komplex mit humanem Transferrin (orange) in voller Länge. PDB 3v8x

RFPCW3PP–Neisseria meningitidis Gehirn Infektion, computer Abbildung. N.-meningitidis-sind Gramnegative diplokokken (kugelförmige Bakterien paarweise angeordnet), über die Atemwege Route übertragen. In den meisten Menschen, die Sie führen entweder asymptomatische Infektionen oder schwere nasopharingitis, können aber auch schwere Meningitis verursachen und generalisierte Infektion (meningococcaemia), besonders bei Kindern. Ihre Oberfläche ist mit pilli, die Teil der in Anhang von Bakterien, Zellen und Oberflächen werden abgedeckt.

RF2WC13X2–Kairo, Ägypten, 11. Januar 2024: Nimenrix-Impfstoff gegen invasive Meningokokken-Krankheit, verursacht durch das Bakterium Neisseria meningitidis und gereinigtes Polum

RF2JAJN00–Biomedizinische Darstellung der Neisseria meningitidis, einer bakteriellen Meningitis, auf schwarzem Hintergrund.

RF2WXRF4A–Die 3D-Rendering von Neisseria meningitidis, auch als Meningokokken bekannt, ist ein Bakterium, das Meningokokken-Erkrankungen verursacht

RF2JT0CM8–Meningitis. Gehirn des Menschen mit Entzündung der Hirnhäute. Krankheitserreger, die diese Krankheit verursacht haben. Die Entzündung, die durch Viren, Bakterien, Pilze verursacht wird

RM2X92BY9–Meningokokken oder Meningokokken-Krankheit oder Neisseria meningitidis, ist ein an Meningitis beteiligtes Bakterium. Diese Bakterien sind die Ursache einer leichten Pharyngitis und nur eine von etwa 400 Personen wird Opfer einer schweren Meningokokkeninfektion, meist in Form einer akuten eitrigen Meningitis. Bild aus optischer Mikroskopie. Meningokokken 016813 024

RMK1FAPX–Neisseria meningitidis, Gruppe C, in der Rückenmarksflüssigkeit, Neisseria meningitidis, Gruppe C, in der Rückenmarksflüssigkeit FA Fleck (digital koloriert) Mit freundlicher CDC/Dr MS Mitchell, 1964.

RF2RND2G9–Meningokokken-Krankheit - bakterielle Infektion, die Meningitis und Sepsis verursachen kann.

RF2RAKK0N–Meningitis-Bakterien, Neisseria meningitidis. Meningokokken-Meningitis ist eine bakterielle Form der Meningitis, eine schwere Infektion der dünnen Auskleidung

RF2R6E5DJ–Meningitis-Bakterien (Neisseria meningitidis), Computerdarstellung. N. meningitidis sind gramnegative Diplokokken (kugelförmige Bakterien paarweise angeordnet

RF2FYN1CG–Meningitis News auf dem Handy.Handy in den Händen. Selektiver Fokus und chromatische Aberration Effekte.

RFPCW3PK–Neisseria meningitidis Gehirn Infektion, computer Abbildung. N.-meningitidis-sind Gramnegative diplokokken (kugelförmige Bakterien paarweise angeordnet), über die Atemwege Route übertragen. In den meisten Menschen, die Sie führen entweder asymptomatische Infektionen oder schwere nasopharingitis, können aber auch schwere Meningitis verursachen und generalisierte Infektion (meningococcaemia), besonders bei Kindern. Ihre Oberfläche ist mit pilli, die Teil der in Anhang von Bakterien, Zellen und Oberflächen werden abgedeckt.

RF2WC14D3–Kairo, Ägypten, 11. Januar 2024: Nimenrix-Impfstoff gegen invasive Meningokokken-Krankheit, verursacht durch das Bakterium Neisseria meningitidis und gereinigtes Polum

RF2C4G0J7–Meningitis-Bakterien (Neisseria meningitidis), Computerdarstellung. N. meningitidis sind gram-negative Diplokokken (paarweise angeordnete sphärische Bakterien), die über die Atemwege übertragen werden. Bei den meisten Menschen verursachen sie entweder asymptomatische Infektionen oder eine nicht schwere Nasopharyngitis, können aber auch schwere Meningitis und generalisierte Infektionen (Meningokokkämie) verursachen, insbesondere bei Kindern. Die Oberfläche von Bakterien ist mit Pilli bedeckt, die eine Rolle bei der Anhaftung von Bakterien an Zellen und Oberflächen spielen.

RM2X92BD5–Meningokokken oder Meningokokken-Krankheit oder Neisseria meningitidis, ist ein an Meningitis beteiligtes Bakterium. Diese Bakterien sind die Ursache einer leichten Pharyngitis und nur eine von etwa 400 Personen wird Opfer einer schweren Meningokokkeninfektion, meist in Form einer akuten eitrigen Meningitis. Bild aus optischer Mikroskopie. Meningokokken 016813 019

RF2SBA9J0–Bakterielle Meningitis konzeptuelle Vektor-Illustration Wortwolke isoliert auf weißem Hintergrund.

RF2RAKK0H–Meningitis-Bakterien, Neisseria meningitidis. Meningokokken-Meningitis ist eine bakterielle Form der Meningitis, eine schwere Infektion der dünnen Auskleidung

RF2R6E5DP–Meningitis-Bakterien (Neisseria meningitidis), Computerdarstellung. N. meningitidis sind gramnegative Diplokokken (kugelförmige Bakterien paarweise angeordnet

RF2WC15DA–Kairo, Ägypten, 11. Januar 2024: Nimenrix-Impfstoff, gereinigtes Polysaccharid gegen invasive Meningokokken-Krankheit, verursacht durch das Bakterium Neisseria meni

RF2C4G0JB–Meningitis-Bakterien (Neisseria meningitidis), Computerdarstellung. N. meningitidis sind gram-negative Diplokokken (paarweise angeordnete sphärische Bakterien), die über die Atemwege übertragen werden. Bei den meisten Menschen verursachen sie entweder asymptomatische Infektionen oder eine nicht schwere Nasopharyngitis, können aber auch schwere Meningitis und generalisierte Infektionen (Meningokokkämie) verursachen, insbesondere bei Kindern. Die Oberfläche von Bakterien ist mit Pilli bedeckt, die eine Rolle bei der Anhaftung von Bakterien an Zellen und Oberflächen spielen.

RM2X92BE9–Meningokokken oder Meningokokken-Krankheit oder Neisseria meningitidis, ist ein an Meningitis beteiligtes Bakterium. Diese Bakterien sind die Ursache einer leichten Pharyngitis und nur eine von etwa 400 Personen wird Opfer einer schweren Meningokokkeninfektion, meist in Form einer akuten eitrigen Meningitis. Bild aus optischer Mikroskopie. Meningokokken 016813 021
RFB6DYNP–Meningitis-Bakterien. Neisseria Meningitidis Kolonien (weiß) auf einem Agar Wachstumsmedium (braun) in einer Petrischale kultiviert wird.

RF2WC13X7–Kairo, Ägypten, 11. Januar 2024: Nimenrix-Impfstoff, gereinigtes Polysaccharid gegen invasive Meningokokken-Krankheit, verursacht durch das Bakterium Neisseria meni

RM2X92ARW–Meningokokken oder Meningokokken-Krankheit oder Neisseria meningitidis, ist ein an Meningitis beteiligtes Bakterium. Diese Bakterien sind die Ursache einer leichten Pharyngitis und nur eine von etwa 400 Personen wird Opfer einer schweren Meningokokkeninfektion, meist in Form einer akuten eitrigen Meningitis. Bild aus optischer Mikroskopie. Meningokokken 016813 020













































